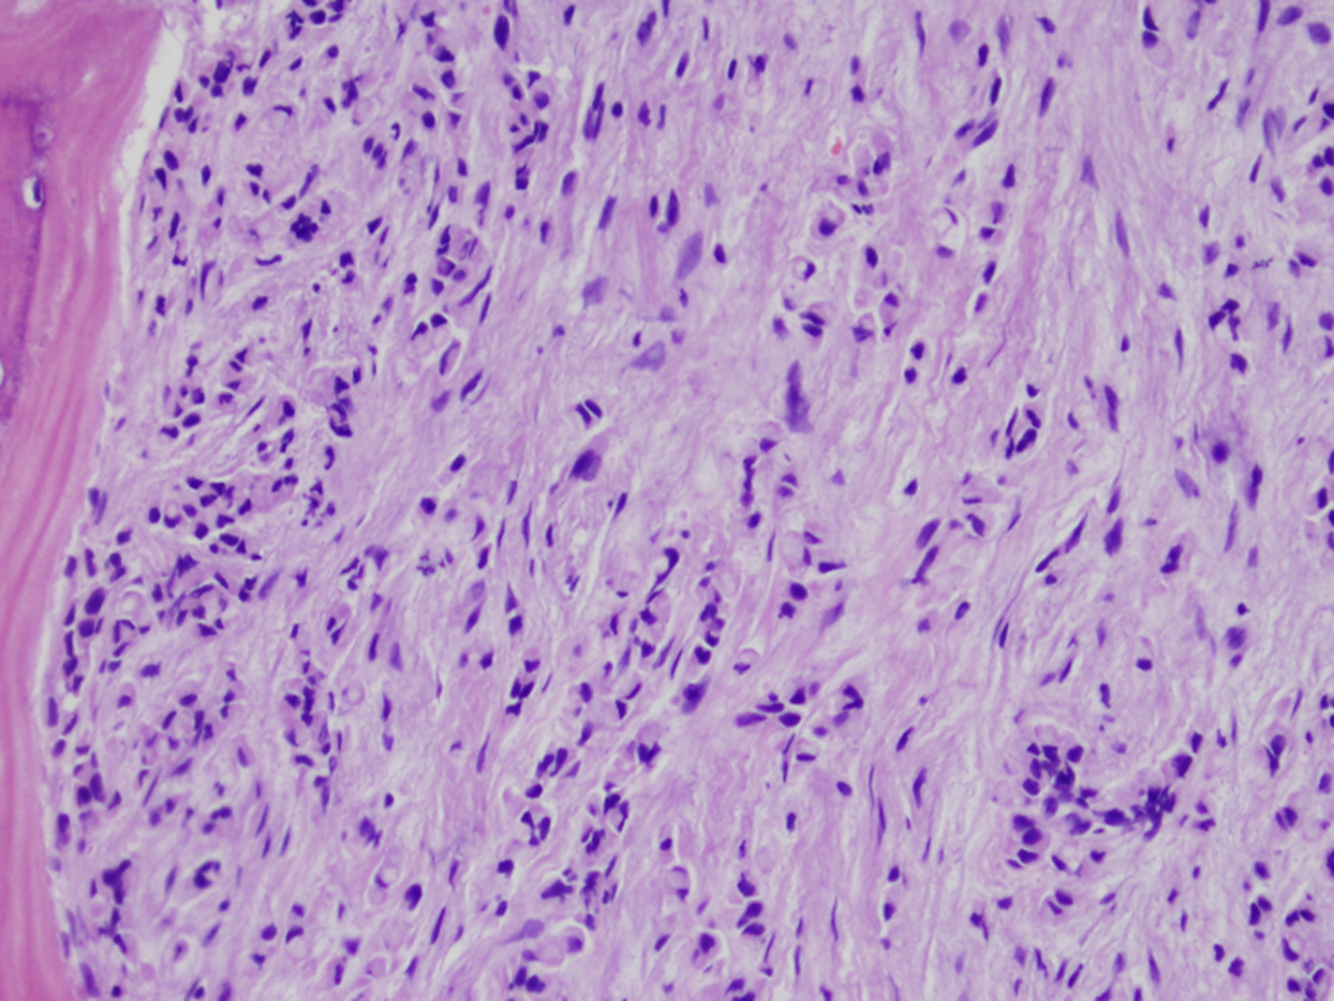
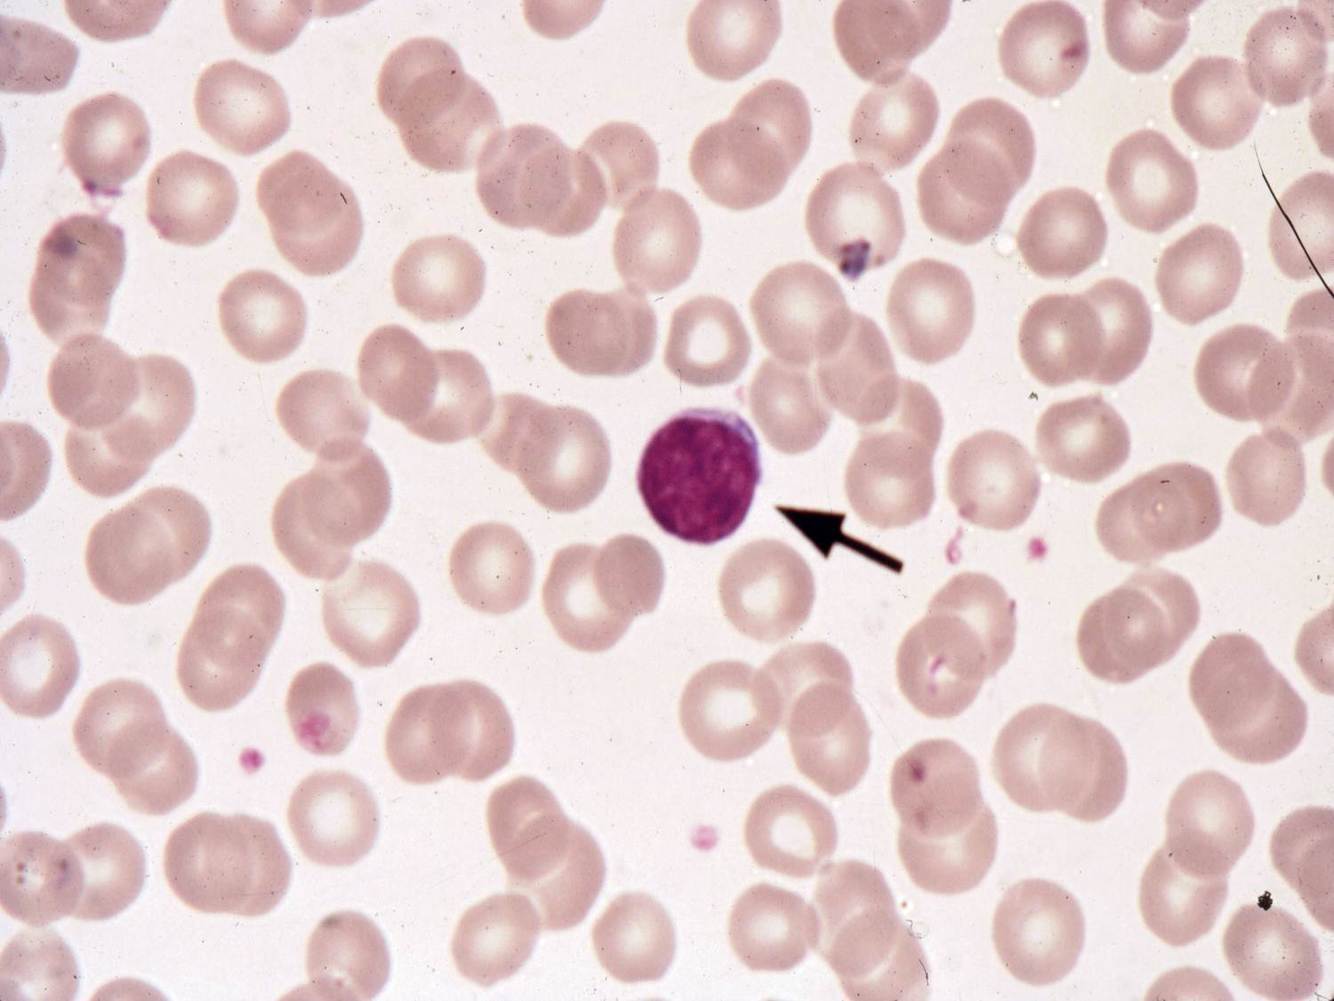
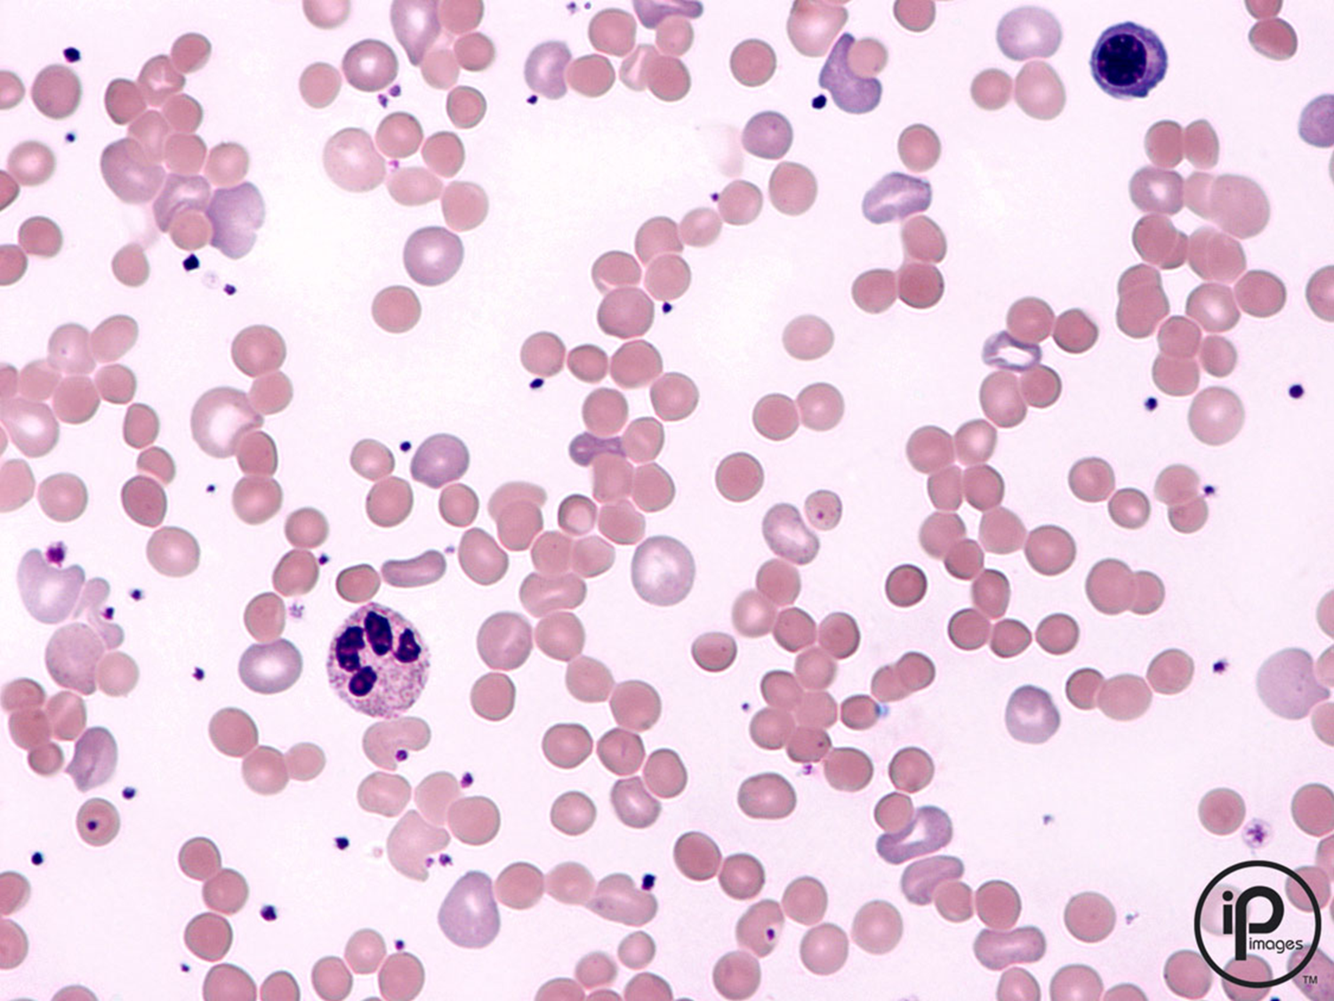
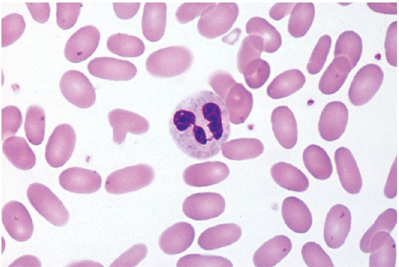
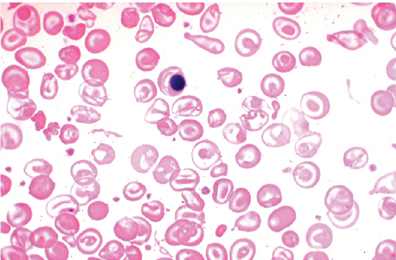
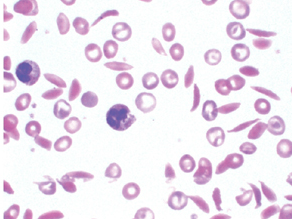
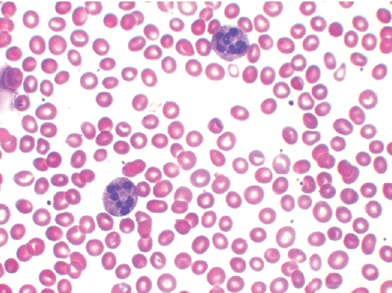

normal or abnormal?

normal bone marrow biopsy

aplastic anemia
BONE MARROW BIOPSY WITH METASTATIC CANCER
describe the RBCs here

normocytic, have a zone of central pallor about 1/3 the size of the RBC. They have minimal variation in size (anisocytosis) and shape (poikilocytosis). A few small blue platelets are seen.
what cell is pointed out here? is it normal or abnormal?
A normal mature lymphocyte is seen. An RBC is seen to be about 2/3 the size of the nucleus of a small lymphocyte.
Increased reticulocytes /polychromatophils

ringed sideroblast, abnormal. Found in lead & zinc poisoning, ethanol toxicity, INH treatment, copper or pyridoxine deficiency, MDS
normal or abnormal neutrophil?

normal
normal or abnormal neutrophil?

abnormal. hypersegmented
what type of anemia

iron deficiency anemia (microcytic, hypochromic)
with increased fragility of RBCs, defect in erythrocyte cytoskeleton. what’s the disease?

hereditary spherocytosis
normocytic anemia, abnormal polymerization of spectrin. what’s the dx?
hereditary elliptocytosis
diagnosis?
beta thalassemia
nucleated RBCs occur in which disease?

hemolytic disease of newborn/erythroblastosis fetalis
diagnosis?
sickle cell disease
what type of RBCs? in what disease?

spur cells. in acanthocytosis (assoc with liver disease)
(hairy cell leukemia/multiple myeloma/myelodysplastic syndrome/polycythemia vera/promyelocytic leukemia)

myelodysplastic syndrome (ringed sideroblasts)
numerous oval macrocytes and hypersegmented neutrophils in an alcoholic
folic acid deficiency
t(9;22)

chronic myelogenous leukemia
smudge cells found in: (ALL/CLL/CML/multiple myeloma/Waldenstrom macroglobulinemia). picture shows more than 80% of WBCs are small lymphocytes.

chronic lymphocytic leukemia
stained for TdT

acute lymphoblastic leukemia
Reed Sternberg cell diagnostic hallmark of:

Hodgkin Lymphoma
what’s shown in this bone marrow biopsy

myelofibrosis
proliferation (in B cell areas/of dendritic cells/of plasma cells/in T cell areas/of marginal zone lymphocytes)

B cell areas. follicular hyperplasia